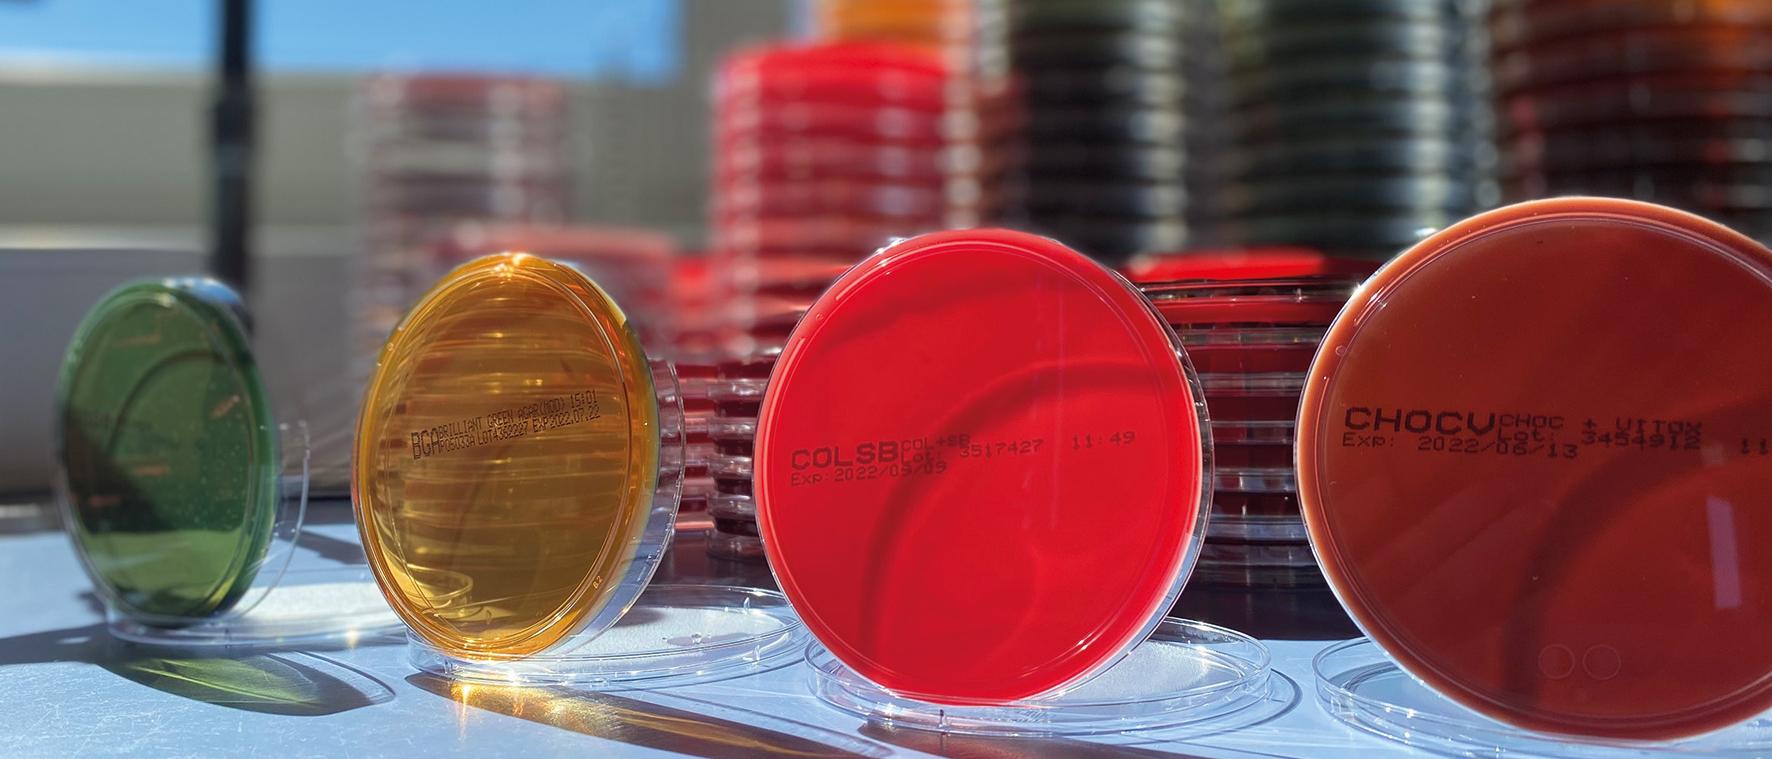
LVL Lebensmittel- und Veterinärlabor GmbH

LVL Lebensmittel- und Veterinärlabor GmbH
Standort
ecopark Allee 6
49685 Emstek
Biologie-Begeisterte aufgepasst!
Du hast Lust uns dabei zu unterstützen, für gute und sichere Lebensmittel zu sorgen? Bei der LVL GmbH führen wir leidenschaftlich Laboranalysen durch. Wir sind spezialisiert auf die Lebensmitteluntersuchung, Futtermittelanalytik, sowie die Veterinärdiagnostik und sind Teil des Labornetzwerks von Normec Foodcare.
Ausbildung zum/zur:
Biologielaborant/ in (m/w/d)
Das bringst du mit:
• Du hast einen Realschulabschluss oder das Abitur
• Du hast Interesse an Biologie bzw. Chemie
• Du bist sehr aufmerksam
• Du arbeitest konzentriert, gewissenhaft und zuverlässig
• Du hast keine Scheu vor Mikroorganismen und Probenmaterial tierischen Ursprungs
Wir freuen uns auf Dich!
Lisanne Wallmeyer
Ansprechpartnerin Ausbildung